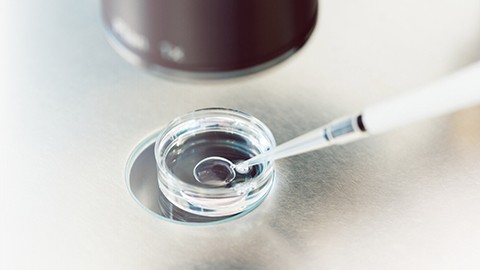

La empresa Ovatec, adherida al Parc de Recerca UAB y surgida de la sexta edición del Programa Generación de Ideas, ha puesto en marcha un laboratorio pionero en Cataluña de producción in vitro de embriones bovinos
Los embriones in vitro mejoran la fertilidad de las granjas, reducen los períodos improductivos, incrementan el valor de los terneros destinados a consumo y aceleran la mejora genética de los rebaños.
Ovatec trabaja en dos líneas de producción de embriones, los embriones de genética, que provienen de vacas donantes seleccionadas, y los embriones provenientes de animales de carne, que potencian la fertilidad de los animales receptores. "Los ganaderos, según la estrategia reproductiva que tengan, pueden elegir entre un embrión de genética propia, comprar embriones de genética de otra granja o bien escoger embriones de carne (en estos momentos de la raza Angus)", explica Maria Gracia Català, cofundadora de la empresa. Aparte, ofrecen servicios de eficiencia reproductiva, pruebas de fertilidad de sementales, cursos de transferencia de embriones, entre otros.
Su laboratorio, que ya está en funcionamiento y les permite producir y comercializar embriones semanalmente, cuenta con equipos de última generación y un sistema de filtrado del aire para evitar contaminaciones provenientes del exterior. Ahora la empresa está perfeccionando la transferencia de los embriones al útero de la vaca para poder mejorar el rendimiento.
Actualmente están empezando a trabajar con la Federació de la Raça Bruna dels Pirineus (FEBRUPI) con el objetivo de mejorar genéticamente la raza y potenciar la Bruna del Pirineo en el territorio. También tienen un convenio de colaboración con la Facultad de Veterinaria de la UAB.
Ovatec, que recibió el tercer premio del Programa Generación de Ideas del Parc de Recerca UAB, la forman Maria Gracia Català, Doctora en Producción Animal de la Facultad de la Veterinaria de la UAB, y Miguel Espada Aventín, comercial con más de diez años de experiencia en el sector de la reproducción animal.